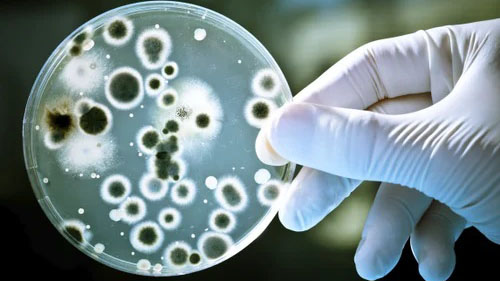

Biopesticides and Bio Fertilisers testing
Biopesticides and biofertilizers play a significant role in sustainable agriculture and environmental protection. Testing of biopesticides and biofertilizers is essential to ensure their efficacy, safety, and compliance with regulatory standards.